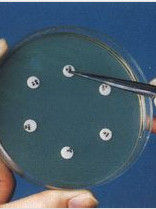
藥敏試驗 藥敏試驗

簡介
體外抗菌藥物敏感性試驗簡稱藥敏試驗(AST),是指在體外測定藥物抑菌或殺菌能力的試驗。
根據美國國家臨床實驗室標準化委員會(NCCLS)近期推薦的標準,對非苛氧菌(腸桿菌科細菌、銅綠假單胞菌、和其他非腸科桿菌、葡萄球菌屬細菌、腸球菌屬細菌)和苛氧菌(嗜血桿菌屬細菌、淋病奈瑟菌、肺炎鏈球菌和其他鏈球菌)選擇常規藥敏試驗的首選藥物(A組抗生素)或臨床使用的主要抗生素(B組抗生素)進行藥敏試驗。
抗菌藥對細菌性傳染病的控制起到了非常重要的作用,但由於養殖過程中不科學的、盲目的濫用抗菌藥,很多致病性細菌產生了耐藥性,使得抗菌藥對細菌性疾病的控制效果越來越差,不但造成藥物浪費,而且還延誤病情,給養殖戶造成了很大的經濟損失。
藥敏試驗隨著新型致病菌的不斷出現,抗菌藥的防治效果越來越差。並且各種致病菌對不同的抗菌藥物的敏感性不同,同一細菌的不同菌株對不同抗菌藥物的敏感性也有差異。長期以來,各種致病菌耐藥性的產生使各種常用抗菌藥物往往失去藥效,以及不能很好的掌握藥物對細菌的敏感度,所以一個正確的結果,可供臨床醫師選用抗菌藥物的參考,並提高療效。農業部動物檢疫所青島易邦生物工程有限公司動物疫病診療中心總結出幾套適合基層進行藥敏試驗的操作方法,現簡單介紹如下。
分類
紙片擴散法該法是將含有定量抗菌藥物的濾紙片貼在已接種了測試菌的瓊脂表面上,紙片中的藥物在瓊脂中擴散,隨著擴散距離的增加,抗菌藥物的濃度呈對數減少,從而在紙片的周圍形成濃度梯度。同時,紙片周圍抑菌濃度範圍內的菌株不能生長,而抑菌範圍外的菌株則可以生長,從而在紙片的周圍形成透明的抑菌圈,不同的抑菌藥物的抑菌圈直徑因受藥物在瓊脂中擴散速度的影響而可能不同,抑菌圈的大小可以反映測試菌對藥物的敏感程度,並與該藥物對測試菌的MIC呈負相關。
稀釋法
稀釋法藥敏試驗可用於定量測試抗菌藥物對某一細菌的體外活性,分為瓊脂稀釋法和肉湯稀釋法。實驗時,抗菌藥物的濃度通常經過倍比(lg2)稀釋,能抑制待測菌肉眼可見生長的最低藥物濃度成為最小抑菌濃度(MIC),一個特定抗菌藥物的測試濃度範圍應該包含能夠檢測細菌的解釋性折點(敏感、中介和耐藥)的濃度,同時也應該包含質控參考菌株的MIC.
2.1瓊脂稀釋法首先製備含抗菌藥物的瓊脂稀釋平板。再接種待測菌株,然後是結果判讀。
2.2肉湯稀釋法
抗生素濃度梯度法
自動化儀器法
3實驗步驟
實驗材料普通營養瓊脂培養基:可去生化試劑店購買,做不同細菌的藥敏試驗可選擇不同的培養基,如做大腸桿菌的藥敏試驗可選擇普通營養瓊脂或麥糠凱培養基。做沙門氏菌可選擇血清培養基。
藥敏試紙:購買或自製(詳見實驗準備)
細菌:待做藥敏試驗的細菌
儀器:接種環、酒精燈、打孔器、牛津杯、移液器、滴頭
實驗準備
2.1 藥敏片的準備:購買或自製
2.1.1 製備方法:取新華1號定性濾紙,用打孔機打成6毫米直徑的圓形小紙片。取圓紙片50片放入清潔乾燥的青黴素空瓶中,瓶口以單層牛皮紙包紮。經15磅15-20分鐘高壓消毒後,放在37℃溫箱或烘箱中數天,使完全乾燥。
2.1.2 抗菌藥紙片製作:在上述含有50片紙片的青黴素瓶內加入藥液0.25毫升,並翻動紙片,使各紙片充分浸透藥液,翻動紙片時不能將紙片搗爛。同時在瓶口上記錄藥物名稱,放37℃溫箱內過夜,乾燥後即密蓋,如有條件可真空乾燥。切勿受潮,置陰暗乾燥處存放,有效期3-6個月。
2.2 藥液的製備(用於商品藥的試驗):按商品藥的使用治療量的比例配製藥液;如商品藥百病消按其說明量治療量0.01%飲水,可按這個比例配製藥液,可取10毫克加入10毫升的水中混勻。此稀釋液即為用於做藥敏試驗的藥液。
實驗操作方法
3.1 藥敏片法
3.1.1 在“超淨台”中,用經(酒精燈)火焰滅菌的接種環挑取適量細菌培養物,以劃線方式將細菌塗布到平皿培養基上。具體方式;用滅菌接種環取適量細菌分別在平皿邊緣相對四點塗菌,以每點開始劃線塗菌至平皿的1/2。然後,找到第二點劃線至平皿的1/2,依次劃線,直至細菌均勻密布於平皿。(另:可挑取待試細菌於少量生理鹽水中製成細菌混懸液,用滅菌棉拭子將待檢細菌混懸液塗布於平皿培養基表面。要求塗布均勻緻密,直接懸液法要把菌液濃度用生理鹽水或PBS調到0.5個麥氏標準再塗布均勻。)
3.1.2 將鑷子於酒精燈火焰滅菌後略停,取藥敏片貼到平皿培養基表面。為了使藥敏片與培養基緊密相貼,可用鑷子輕按幾下藥敏片。為了使能準確的觀察結果,要求藥敏片能有規律的分布於平皿培養基上;一般可在平皿中央貼一片,外周可等距離貼若干片(外周一般可貼七片),每種藥敏片的名稱要記住。
3.1.3 將平皿培養基置於37℃溫箱中培養24小時後,觀察效果。
3.2 牛津杯法
3.2.1 在“超淨台”中,用經(酒精燈)火焰滅菌的接種環挑取適量細菌培養物,以劃線方式將細菌塗布到平皿培養基上。具體方式;用滅菌接種環取適量細菌分別在平皿邊緣相對四點塗菌,以每點開始劃線塗菌至平皿的1/2。然後,找到第二點劃線至平皿的1/2,依次劃線,直至細菌均勻密布於平皿。(另:可挑取待試細菌於少量生理鹽水中製成細菌混懸液,用滅菌棉拭子將待檢細菌混懸液塗布於平皿培養基表面。要求塗布均勻緻密。)
3.2.2 以無菌操作將滅菌的不鏽鋼小管(內徑6nm、外徑8nm、高10nm的圓形小管,管的兩端要光滑,也可用玻璃管、瓷管),放置在培養基上,輕輕加壓,使其與培養基接觸無空隙,並在小管處標記各種藥物名稱。每個平板可放4-6支小管。待分鐘後,分別向各小管中滴加一定數量的各種藥液,勿使其外溢。置37℃培養8-18小時,觀察結果。
3.2.3 將平皿培養基置於37℃溫箱中培養24小時後,觀察效果。
3.3 打孔法:
該法較簡單,成本低,易操作,比較適用於商品藥物的檢測。
3.3.1 在“超淨台”中,用經(酒精燈)火焰滅菌的接種環挑取適量細菌培養物,以劃線方式將細菌塗布到平皿培養基上。具體方式;用滅菌接種環取適量細菌分別在平皿邊緣相對四點塗菌,以每點開始劃線塗菌至平皿的1/2。然後,找到第二點劃線至平皿的1/2,依次劃線,直至細菌均勻密布於平皿。(另:可挑取待試細菌於少量生理鹽水中製成細菌混懸液,用滅菌棉拭子將待檢細菌混懸液塗布於平皿培養基表面。要求塗布均勻緻密。)
3.3.2 以無菌操作將滅菌的不鏽鋼小管(外徑為4毫米、孔徑與孔距均為3毫米,管的兩端要光滑,也可用玻璃管、瓷管),放置在培養基上打孔,將孔中的培養基用針頭挑出,並以火焰封底,使培養基能充分的與平皿融合(以防藥液滲漏,影響結果)。
3.3.3 加樣:按不同藥液加樣,樣品加至滿而不溢為止。
3.3.4 將平皿培養基置於37℃溫箱中培養24小時後,觀察效果。
結果觀察
在塗有細菌的瓊脂平板上,抗菌藥物在瓊脂內向四周擴散,其濃度呈梯度遞減,因此在紙片周圍一定距離內的細菌生長受到抑制。過夜培養後形成一個抑菌圈,抑菌圈越大,說明該菌對此藥敏感性越大,反之越小,若無抑菌圈,則說明該菌對此藥具有耐藥性。其直徑大小與藥物濃度、劃線細菌濃度有直接關係。判定標準
一、藥敏實驗的結果,應按抑菌圈直徑大小作為判定敏感度高低的標準。表1 藥物敏感實驗判定標準
抑菌圈直徑(毫米)
敏感度
藥敏試驗20以上
極敏
15~20
高敏
10~14
中敏
10以下
低敏
0
不敏
具體對於不同的菌株,及不同的抗生素紙片需參照NCCLs的標準或者CLSI標準。
二、藥物敏感實驗判定標準參考表1,多黏菌素抑菌圈;在9毫米以上為高敏,6—9毫米為低敏,無抑菌圈為不敏。
影響因素
培養基細菌藥敏試驗所用的培養基種類較多,多數情況下,採用WHO組織統一要求的M—H培養基,這種培養基中含有的低胸腺嘧啶是與磺胺類藥物競爭的物質,因此進行的藥敏試驗效果較好。此外,還有適量的Ca、Mg,在培養基中起到觸媒的作用。但是,有些細菌對培養基中的成分有特殊的要求,特殊的菌要用特殊的培養基才能進行藥敏試驗。例如,流感嗜血桿菌的藥敏試驗培養基用HTM瓊脂;淋球菌的藥敏試驗培養基用加5%羊血的朱古力M—H瓊脂;肺炎鏈球菌的藥敏實驗用M—H瓊脂加5%的脫纖維羊血培養基。培養基中還有適量的Ca、Mg,在培養基中起到溶酶的作用,其含量的變化,可影響氨基糖苷類和四環素對銅綠假單胞菌的試驗結果,含量過高,抑菌圈會變小,含量過低,抑菌圈會大得不可接受。
細菌藥敏試驗的培養基厚度大約為4mm,若培養基厚度大於4mm,會使細菌出現耐藥;若小於4mm,本應耐藥的易出現敏感。所以,試驗時一定不要把藥敏紙片放在中央部位,而應均勻地排布在平皿周圍的培養基上。製作藥敏試驗的培養基用水,主要是Ca、Mg、A1等礦物質離子,也在很大程度上影響著藥敏試驗的結果。
試紙片
試紙片材質的好壞,對藥物穩定性和活性有很大影響。加工藥敏試紙片的試紙一般是使用加厚型的濾紙,雜質少,對藥物保存無太大影響。然而,臨床中很多用的是普通紙,被水浸潤後會呈鹼性,並且含有大量無機離子,因此使用普通紙加工的試紙片藥物有較大的影響。藥敏紙片的pH值一般要求為中性,這樣才適合藥的活度。藥敏紙片的厚度要求大約1mm,這樣才有利於細菌的生長和藥物的擴散速度。藥敏紙片的直徑在6.00~6.35mm之間,紙片的厚度和直徑大小都會影響藥敏試驗的結果。
含藥紙片的片間差和質量好壞是做藥敏試驗的關鍵。一些藥敏紙片買來時就有抑菌環偏大或偏小的問題,紙片之間又存在很大的片間差。因此,紙片在用前必須檢驗其片間差和準確度,只有都達到標準要求後才能使用。同時要注意紙片的保存,因為有的紙片,如青黴素類,在保存中因為受潮濕環境的影響容易降低其藥物的活性。因此,紙片應放低溫下(-10℃)保存,同時要避免潮濕,以保持抗菌藥物的活性。盛紙片小瓶自低溫處取出應在室溫平衡至少10min後再打開,避免冷凝水影響藥效。
細菌
由於各種菌對藥物的敏感性不同,產生的抑菌環大小不同,如果菌種不純,試驗中所產生的抑菌環大小與該菌種在純培養狀態下產生的抑菌環大小存在較大的差異,影響判斷結果的準確性。因此需要對各種致病菌提純後,分別進行不同的藥敏試驗。藥敏試驗時,需要將提純後的菌種配製成一定濃度的菌液。WHO組織制定的標準是要求菌液濃度在1.5億/ml左右。若菌液濃度過高,該菌會對所有藥物產生耐藥;反之,菌液濃度過低,該菌會對所有藥物均敏感。最精確的方法是使用分光光度計測定新鮮培養物菌懸液的吸光度,來確定菌液濃度。國家細菌耐藥性監測網的三級甲等醫院,其微生物實驗室大多數用此法來確定藥敏試驗的菌液濃度。
藥敏試驗中要將菌液均勻地塗在培養基上,使細菌均勻分布,這樣才能使試驗結果不會出現較大的偏差。塗菌後15min才能貼藥敏紙片。由於塗菌後,細菌要有一段時間的適應過程,但是時間不能過長,否則會使細菌產生耐藥。貼藥敏紙片時,每取一種藥敏紙片必須燒一下鑷子口,避免藥敏紙片之間相互混淆,以提高藥敏的準確性。藥物殺滅細菌存在一定的量比,藥敏試驗培養基上細菌層越厚抑菌圈就越小,反之抑菌圈就越大。根據一種藥物抑菌圈的有無或者大小,只能判斷出該藥對細菌有沒有效果,但其敏感性的高低需要通過科學嚴謹的實驗來確定。藥物的敏感程度需要根據藥敏試驗的結果,並結合以上因素做綜合分析,才能得出科學的結論,而片面地根據藥敏圈的大小來決定敏感與否,結果不夠準確。[1]
培養時間
一般培養溫度和時間為37℃8-18小時,有些抗菌藥擴散慢如多粘菌素,可將已放好抗菌藥的平板培養基,先置4℃冰櫃內2~4小時,使抗菌藥預擴散,然後再放37℃溫箱中培養,可以推遲細菌的生長,而得到較大的抑菌圈。